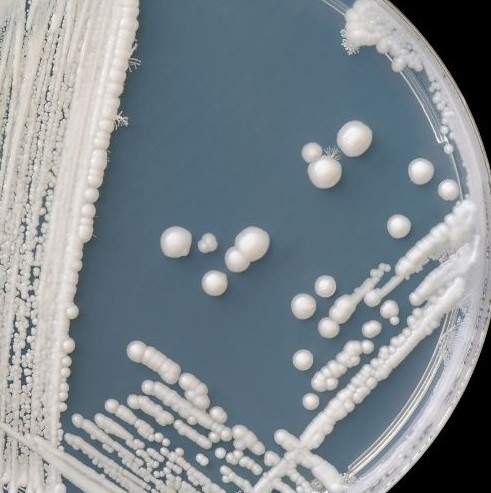

One of the most confusing things for patients is this:
They have symptoms that look exactly like Candida —
but their tests come back “normal.”
Today I want to explain why Candida often doesn’t show up on tests, and why that doesn’t mean it isn’t there.
I’ve been treating IBS and related conditions like Candida for over 25 years, and I founded the IBS Treatment Center in 2005, where we’ve helped more than 10,000 patients recover.
And this is something we explain to patients every single week.
Most people assume that if a test is negative, the problem isn’t real.
But in functional and digestive medicine, that assumption often breaks down.
Candida is especially tricky because its behavior doesn’t fit neatly into standard testing models.
So let’s talk about why.
Many Candida tests rely on detecting yeast that’s actively being shed.
But Candida doesn’t shed consistently.
It can:
So you can test on a “quiet” day —
and miss it entirely.
We see this all the time.
Stool testing is useful — but it’s not perfect.
Candida may:
So a normal stool test does not rule out Candida.
It simply means it wasn’t detected that day, in that sample.
Blood tests look for systemic infection or immune reactions.
But intestinal Candida is often localized to the gut, not the bloodstream.
So blood tests are frequently normal —
even when symptoms are severe.
This leads to a very common and very frustrating message:
“Your labs are normal. Everything looks fine.”
When the patient clearly does not feel fine.
This is the key point.
Candida is rarely diagnosed by one test.
We look at:
When someone’s symptoms improve in a predictable way with antifungal strategies —
that response itself becomes diagnostic.
That’s something no single lab test can replace.
Because tests are often normal, patients get labeled with:
Meanwhile, the underlying yeast imbalance continues.
This is why so many people spend years bouncing between doctors without answers.
At the IBS Treatment Center, we don’t rely on one test in isolation.
We combine:
This is how we’ve helped thousands of patients who were told their tests were normal —
but their lives clearly weren’t.
If you’ve been told your tests are normal —
but your symptoms persist —
that doesn’t mean nothing is wrong.
Candida may still be part of the picture.
This is exactly what we do at the IBS Treatment Center.
We work with patients across the U.S. and around the world through telemedicine, and we’ve been doing this since 2005.
And remember — take good care of your body.
It’s the only place you have to live. ❤️
Candida vs IBS — How to Tell the Difference
Candida Symptoms People NEVER Connect to Yeast
Seattle: 206-264-1111
Los Angeles: 310-319-1500
Our WhatsApp: 206-791-2660
Copyright © 2026 IBS TREATMENT CENTER. All Rights Reserved
Lorem ipsum dolor sit amet, consectetur adipiscing elit. Suspendisse varius enim in eros elementum tristique. Duis cursus, mi quis viverra ornare, eros dolor interdum nulla, ut commodo diam libero vitae erat. Aenean faucibus nibh et justo cursus id rutrum lorem imperdiet. Nunc ut sem vitae risus tristique posuere.